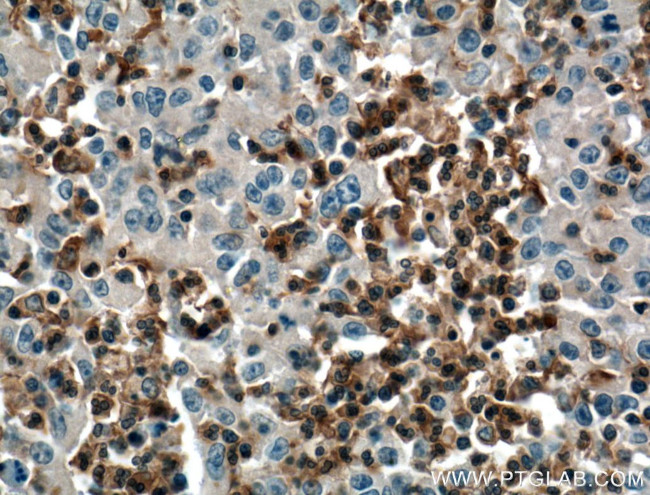
SKAP2 Antibody in Immunohistochemistry (Paraffin) (IHC (P))

Search
Proteintech
SKAP2 Polyclonal Antibody
{{$productOrderCtrl.translations['antibody.pdp.commerceCard.promotion.promotions']}}
{{$productOrderCtrl.translations['antibody.pdp.commerceCard.promotion.viewpromo']}}
{{$productOrderCtrl.translations['antibody.pdp.commerceCard.promotion.promocode']}}: {{promo.promoCode}} {{promo.promoTitle}} {{promo.promoDescription}}. {{$productOrderCtrl.translations['antibody.pdp.commerceCard.promotion.learnmore']}}
产品信息
12926-1-AP
种属反应
已发表种属
宿主/亚型
分类
类型
抗原
偶联物
形式
浓度
规格
纯化类型
保存液
内含物
保存条件
运输条件
产品详细信息
Immunogen sequence: MPNPSSTSS PYPLPEEIRN LLADVETFVA DILKGENLSK KAKEKRESLI KKIKDVKSIY LQEFQDKGDA EDGEEYDDPF AGPPDTISLA SERYDKDDEA PSDGAQFPPI AAQDLPFVLK AGYLEKRRKD HSFLGFEWQK RWCALSKTVF YYYGSDKDKQ QKGEFAIDGY SVRMNNTLRK DGKKDCCFEI SAPDKRIYQF TAASPKDAEE WVQQLKFVLQ DMESDIIPED YDERGELYDD VDHPLPISNP LTSSQPIDDE IYEELPEEEE DSAPVKVEEQ RKMSQDSVHH TSGDKSTDYA NFYQGLWDCT GAFSDELSFK RGDVIYILSK EYNRYGWWVG EMKGAIGLVP KAYIMEMYDI (1-359 aa encoded by BC036044)
靶标信息
Fyb (Fyn binding protein) and the anchoring proteins SKAP55 and SKAP55-R (SKAP55-related protein) associate with the tyrosine kinase p59fyn. SKAP55 and SKAP55-R bind to Fyb through their SH3 domains and function as substrates for p59Fyn in resting T cells. SKAP55 contains an N-terminal pleckstrin homology domain and a C-terminal SH3 domain binding motif of adjacent arginine and lysine residues followed by tandem tyrosines (i.e. RKxxYxxY). SKAP55-R, similar in overall structure to SKAP55, contains a coiled-coil N-terminal domain. SKAP55 associates with SLAP-130, another component of the Fyn complex, which plays a role in the regulation of signaling events initiated by lymphocyte antigen receptors leading up to T cell activation. The human SKAP55 gene maps to chromosome 17q21.32 and encodes a 359 amino acid protein.
仅用于科研。不用于诊断过程。未经明确授权不得转售。
生物信息学
蛋白别名: Fyn-associated phosphoprotein SKAP55 homologue; MGC10411; MGC33304; Pyk2/RAFTK-associated protein; Retinoic acid-induced protein 70; SKAP-55HOM; SKAP-HOM; SKAP55 homolog; SKAP55 homologue; SKAP55-HOM; src family associated phosphoprotein 2; Src family-associated phosphoprotein 2; Src kinase-associated phosphoprotein 2; Src kinase-associated phosphoprotein 55-related protein; src kinase-associated phosphoprotein of 55-related protein; Src-associated adapter protein with PH and SH3 domains; Src-associated adaptor protein; unnamed protein product
基因别名: 2610021A10Rik; AA960083; BB137539; mSKAP55R; PRAP; RA70; SAPS; SCAP2; Scap55r; SKAP-HOM; SKAP2; SKAP55R
UniProt ID: (Human) O75563, (Rat) Q920G0, (Mouse) Q3UND0
Entrez Gene ID: (Human) 8935, (Rat) 155183, (Mouse) 54353